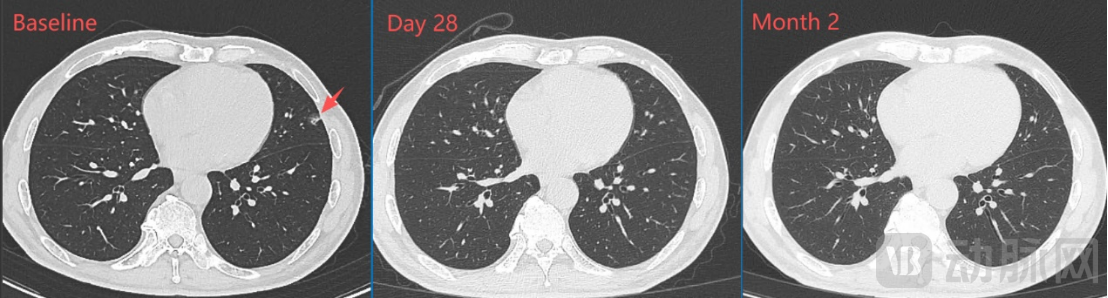
图片5.png

近日获悉,上海镔铁生物科技有限责任公司(以下简称“上海镔铁生物”)自主研发的IX001 TCR-T注射液,2024年10月获得CDE批准开展治疗晚期胰腺癌的I期临床试验,目前已顺利完成首例受试者入组给药及剂量限制性毒性(DLT)观察。
2025年3月27日,上海镔铁生物自主研发的 “IX001 TCR-T注射液” I期临床试验正式启动。启动会由中山大学肿瘤防治中心徐瑞华院长主持,项目的主要研究者李宇红主任、I期病房阮丹云主任带领专业队团成员参会,围绕IX001 TCR-T注射液治疗复发或难治性胰腺癌临床试验的研究方案、检测、项目计划等进行了深入讨论,就临床试验执行中的具体工作流程和重点事项进行了详细沟通。
IX001 TCR-T注射液是上海镔铁生物自主研发,具有独立知识产权的细胞治疗产品,用于治疗基因型为HLA-A*11:01、肿瘤抗原KRAS G12V表达阳性的晚期胰腺癌,有望为晚期实体瘤患者提供全新的治疗选择。
目前,IX001 TCR-T注射液安全性数据良好且展现出非常积极的初步疗效,为后续临床试验的推进奠定了坚实基础。

仅用28天!首例患者达到部分缓解
首例入组的患者是一名62岁男性,2022年8月确诊为胰腺导管腺癌,先后接受3线标准治疗后无效,疾病进展后入组IX001 TCR-T临床试验。研究团队通过基因检测技术发现其肿瘤存在KRAS G12V突变且表达匹配的HLA亚型,在GMP级别生产车间制备出靶向G12V突变的IX001 TCR-T注射液后,清淋后对患者进行单次TCR-T细胞输注治疗。

患者接受TCR-T细胞单次输注和IL-2连续注射,一周后即顺利出院,截止目前已随访至回输后两个月。临床结果显示:安全性良好,患者生命体征平稳、器官功能指标正常,仅在IL-2注射期间出现发热,清淋引起的血细胞减低在一周内快速恢复,未出现2级以上细胞因子释放综合征(CRS)或神经毒性等细胞治疗常见副作用,未观察到DLT。
经流式细胞术检测PK,TCR-T细胞在患者体内快速扩增,在第7天达到峰值,而后缓慢下降,第56天仍能检测到明显的细胞存续。肿瘤标志物CA19-9在回输后7天开始明显下降,仅用28天从基线期的889 U/mL恢复至正常值。
一个月的影像学检查显示:肝门区靶病灶明显缩小、肺部靶病灶基本完全消失,靶病灶直径之和从基线期的67mm缩小至43mm(下降35.8%),按RECIST1.1标准评估已达到部分缓解(PR);两个月的影像学检查显示:肿瘤病灶维持PR,且靶病灶直径之和进一步缩小至35mm(下降47.8%)。

更高特异性+更强抗肿瘤活性,IIT临床已显潜力

上海镔铁生物科技有限责任公司成立于2021年,是一家专注于实体瘤TCR-T细胞治疗并处于临床阶段的生物技术公司。镔铁生物专注自主发现识别肿瘤基因突变(KRAS)的TCR,并推动 TCR-T细胞治疗的技术优化和临床应用。
公司早期开展的IIT临床研究已显示出TCR-T细胞治疗多种实体瘤的初步疗效和安全性,展现出TCR-T在实体瘤领域的巨大潜力。公司拥有一支由多位细胞治疗领域资深专家带领的高精尖团队,具备从实验室的基本发现到临床应用的快速研发和转化能力。公司成立以来已申请多项核心业务相关专利,入选“国家科技型中小企业”、作为子课题负责人获得2023年度国家重点研发计划“前沿生物技术”联合申报项目,作为企业合作单位参与2025年度国家卫生健康委员会重大专项“基于个体化精准测评的肝癌系统治疗策略临床研究“。
2025年6月28-29日,第二届华夏肿瘤免疫治疗新技术论坛暨中国医疗保健国际交流促进会肿瘤免疫治疗学分会2025年年会在郑州圆满举行。上海镔铁生物首席科学家胡红明博士受邀出席论坛,以TCR-T细胞治疗技术为主要方向做新技术展示报告。与此同时,上海镔铁生物荣获第二届肿瘤免疫治疗新技术展示“第一名”。
胡红明博士表示, TCR-T疗法在实体瘤治疗中具有独特优势,可靶向传统抗体药物无法触及的细胞内抗原,IX001 TCR-T注射液” 通过基因修饰技术,将能够特异性识别KRAS G12V突变的TCR基因序列转入T细胞,使其能够精准识别并有效杀伤胰腺癌细胞。与传统疗法相比,TCR-T疗法具有更高的特异性和更强的抗肿瘤活性。
上海镔铁生物将秉承“创新、合作、共赢”的发展理念,与全球生物医药领域的合作伙伴携手共进,共同推动肿瘤细胞免疫治疗技术的创新与发展,延长复发难治肿瘤患者的生存期、实现临床获益。
IX001 TCR-T项目是一项单臂,开放性的I期临床试验,旨在评价IX001 TCR-T注射液在KRAS G12V突变的晚期胰腺癌患者中的安全性、耐受性与初步有效性。计划全国招募9~12例晚期胰腺癌受试者。
● 主要入组标准:
1. 年龄18~75岁(含临界值);
2. 经病理学(组织学)或细胞学确诊的胰腺导管腺癌;
3. 经标准治疗失败的局部晚期或转移性患者;
4. 存在KRAS G12V突变且为HLA-A*11:01亚型;
● 入组联系方式:
联系电话:18127912755 华武老师
联系地址:中山大学附属肿瘤医院越秀院区
● 温馨提示:为了提高研究者的审核效率,建议提前收集整理好如下材料,一旦审核通过,有机会迅速入组接受TCR-T细胞治疗:
1、近期影像报告和肿瘤标志物报告;
2、近期血常规、血生化、凝血功能报告;
3、肿瘤相关基因筛查报告(需包含KRAS);
4、近期传染病报告、既往病史和治疗史;
5、人白细胞抗原HLA分型报告(如有)。

















